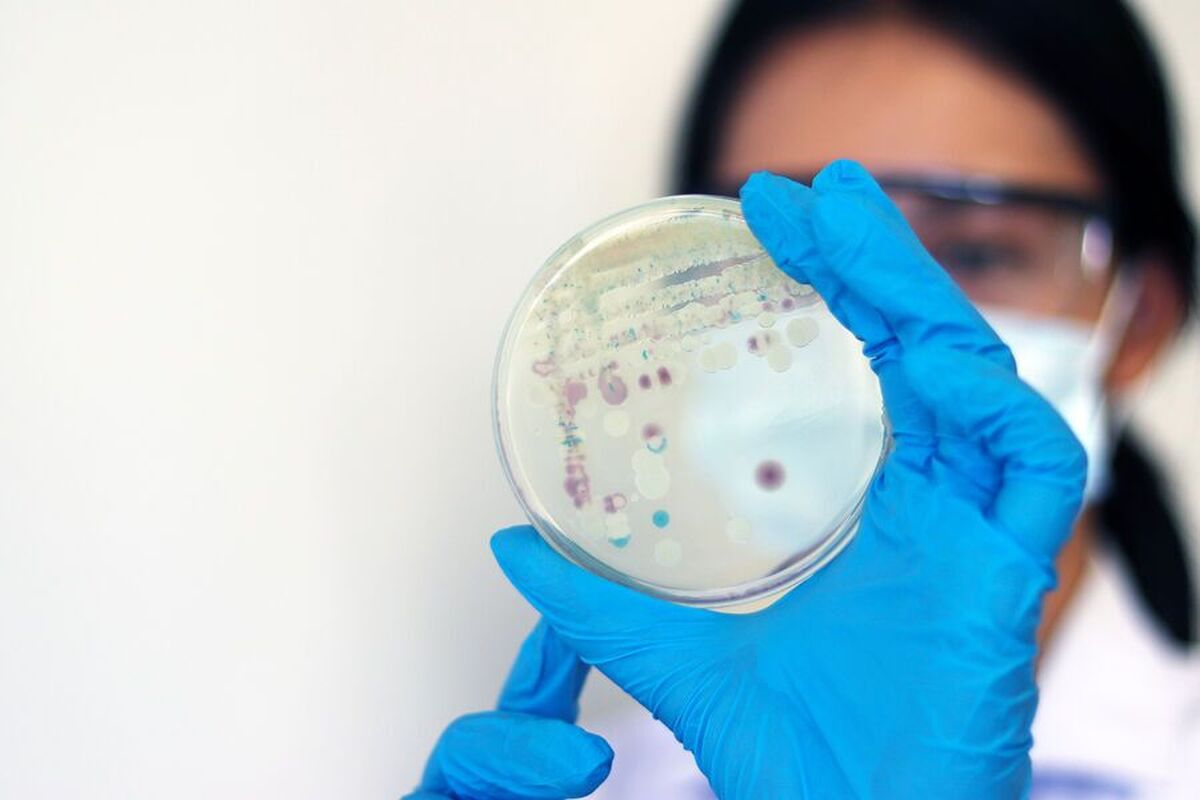
یک قارچ ۴۰۷ میلیون ساله در اسکاتلند کشف شد.

یک قارچ ۴۰۷ میلیون ساله در اسکاتلند کشف شد.
به گزارش مجله خبری نگار،دانشمندان آزمایشگاه سینزبری در دانشگاه کمبریج (SLCU) گونه جدیدی از قارچ همزیست باستانی را کشف کردهاند که در یک فسیل گیاهی با قدمت تقریبی ۴۰۷ میلیون سال حفظ شده است. این میکروارگانیسم در شیل ویندفیلد در اسکاتلند کشف شد. نتایج این مطالعه در مجله New Phytologist (NewPhy) منتشر شده است.
این کشف شواهدی از یکی از اولین تعاملات بین گیاهان و قارچها - میکوریزا - ارائه میدهد. این رابطه همزیستی شامل جذب آب و مواد مغذی توسط قارچها و تامین قند توسط گیاهان توسط گیاهان است. این همکاری زیربنای اکثر اکوسیستمهای مدرن است و نقش حیاتی در تغذیه گیاهان ایفا میکند.
این گونه قارچی جدید Rugososporomyces lavoisierae نامگذاری شد. این گونه با گیاه باستانی Aglaophyton majus رابطه همزیستی برقرار کرد و به دومین قارچ شناخته شده مرتبط با این گونه تبدیل شد.
دانشمندان برای مطالعه این نمونه از تکنیکهای میکروسکوپی مدرن استفاده کردند که به آنها امکان تمایز بین سلولهای قارچی و گیاهی را داد. تجزیه و تحلیل نشانههای نوری - "اثر انگشت نوری" منحصربهفرد بافتهای باستانی - به تأیید وجود قارچ حتی صدها میلیون سال پس از ناپدید شدن DNA آن کمک کرد.
دکتر کریستین استرول-درین، سرپرست این مطالعه، توضیح داد: «وجود آربوسکولها (ساختارهای شاخهدار و نخمانندی که روی قارچها یافت میشوند) نشان میدهد که قارچ انگل گیاه نبوده، بلکه در یک رابطهی سودمند متقابل با آن همزیستی داشته و مواد معدنی مانند فسفر را با قندها مبادله میکرده است. این کشف به ما کمک میکند تا بفهمیم چگونه گیاهان و قارچها در خشکی همزیستی داشتهاند و اکوسیستمهایی را تشکیل دادهاند که پایه و اساس زندگی مدرن را تشکیل دادهاند.»
- لطفا از نوشتن با حروف لاتین (فینگلیش) خودداری نمایید.
- از ارسال دیدگاه های نا مرتبط با متن خبر، تکرار نظر دیگران، توهین به سایر کاربران و ارسال متن های طولانی خودداری نمایید.
- لطفا نظرات بدون بی احترامی، افترا و توهین به مسئولان، اقلیت ها، قومیت ها و ... باشد و به طور کلی مغایرتی با اصول اخلاقی و قوانین کشور نداشته باشد.
- در غیر این صورت، «نگارمگ » مطلب مورد نظر را رد یا بنا به تشخیص خود با ممیزی منتشر خواهد کرد.




- آخرین اخبار
- محبوب
- برچسب های داغ
- ویدئو| فیلمی از یک بازیگر مشهور آمریکایی که در هالیوود بیش از حد مواد مخدر مصرف میکند
- چرا زنان در پنهان کردن ناراحتیهای روانی خود تا این حد ماهر هستند؟
- یک زن آمریکایی در یک خودروی خودران زایمان کرد و این خودرو او را با خیال راحت به بیمارستان منتقل کرد
- عکس| یک بمب خبری جدید در ماجرای صلاح: یک ملاقات مرموز در لندن سوالات بیشتری را مطرح میکند
- عکس| کاخ سفید توضیح میدهد که چرا ترامپ دائماً دست خود را باندپیچی میکند
- روشی عجیب برای ترک دائمی سیگار!
- ویدئو| هند مسی را جشن میگیرد: رونمایی از بزرگترین مجسمه یک ستاره فوتبال زنده
- ماه عسل: چقدر طول میکشد و بعد از آن چه میشود؟
- خشونت علیه زنان و کودکان: یک اپیدمی پنهان که سلامت جهانی را ویران میکند
- «آداب عروسی» میتواند به کاهش استرس و جلوگیری از احساسات منفی یا سوءتفاهمها کمک کند
- قورت دادن آدامس! چه اتفاقی برای بدن شما میافتد؟
- ویدئو| اسپانیا: چهار نفر پس از برخورد موج قدرتمند به یک استخر طبیعی کشته شدند
- ویدئو| بریژیت مکرون فعالان فمینیست را "زنان کثیف و احمق" توصیف میکند
- انتظار میرود طوفان بایرون ظرف ۲۴ ساعت خاورمیانه را درنوردد و هشدارهایی مبنی بر بارش شدید باران و جاری شدن سیل گسترده صادر شده است
- ساعات خواب «طلایی»
- هفت عادت ساده برای افزایش طول عمر و بهبود کیفیت زندگی
- مطالعه: تماشای آثار هنری اورجینال در گالریها فوراً استرس را کاهش میدهد
- مطالعه: لحظات شادی مشترک، هورمونهای استرس را در زوجها کاهش میدهد
- آیا پیادهروی در مناطق شهری میتواند همان مزایای پیادهروی در طبیعت را داشته باشد؟
- نیویورکیها بیشتر از کل کشورهای اروپایی برای سایتهای پورن هزینه میکنند
- دیابت در صورت عدم کنترل به چه اعضایی آسیب میزند؟
- نسل Z درگیر چالشهای بازار کار میشوند!
- ارتباطات اجتماعی بر مغز افراد تاثیر دارد!
- فناوری نوین الکتروشیمیدرمانی ۶ نوع سرطان را درمان خواهد کرد!
- یدید نقره ترکیبی طلایی برای برنامههای تغییر آبوهوا!
- ترکیب نوشیدنی که فشاری برای سلامتی است!
- علائم هشداردهنده آرتروز را جدی بگیرید!
- راهی تازه برای درمان اختلالات شناختی به کمک تغییر در سیناپس!
- طراحی داروهای ضدباکتری به کمک هوش مصنوعی!
- ایلان ماسک قصد فروش سهام خود را دارد!
- آشنایی با یک سیستم ستارهای بسیار درخشان که در آینده ابرنواختر خواهد شد!
- هوش مصنوعی در سفر و گردشگری چه تغییراتی میتواند ایجاد کند؟
- مصرف طولانی مدت روغن چه معایبی دارد؟
- مغز انسان چه نقاط مشترکی با خزندگان دارد؟
- دو ویژگی که کپسولهای امگا۳ باید داشته باشند!
- کاوشگر مریخ دچار مشکل شده است!
- سبکهای مختلف فرزندپروری بر خودکشی افراد تاثیر دارد!
- ادویهها میتوانند سیستم ایمنی را تقویت کنند!
- سه ماهواره ایرانی برای تصویربرداری به فضا پرتاب میشوند!
- برای جلوگیری از سفیدی مو چی بخوریم؟
- استراحت و مصرف مایعات دو اصل اساسی برای شکست بیماری ها!
- آلودگی هوا چه تاثیرات منفی بر سلامتی دارد؟
- این رژیم غذایی میتواند برای دیابت بهترین انتخاب باشد!
- جامعه مصر باستان تریاک مصرف میکردند!
- کمبود آهن در زنان ورزشکار چه عوارضی در پی دارد؟
- عفونتهای تنفسی مربوط به کدام بیماریاند؟
- چرا آغوشهای گرم حس خوبی به انسان میدهد؟
- اختلالت روانی ریشه ژنتیکی دارند!
- ژنتیک نقشی بسیار پررنگ در ابتلا به نقرس دارد!
- استفاده نوجوانان از چتباتهای هوش مصنوعی باعث انزوا میشود!
- دکتری فیزیک کوانتومی برای یک نوجوان ۱۵ ساله!
- نسخه جدید مرورگر کروم ۲ وبسایت متفاوت را بهصورت همزمان نمایش میدهد!
- مغز انسان در خواب هم فعال است!
- سن شروع مصرف دخانیات به ۱۳ سالگی رسیده است!
- گزارش سالانه مکالمات خود با هوش مصنوعی را دریافت کنید!
- معرفی یک جایگزین سالم برای برنج!
- نان خمیر ترش برای تنظیم قند خون مناسب است!
- اولین حس بعد از شروع پرواز از کجا نشات میگیرد؟
- مادران برای روز مادر چه میخواهند؟
- اختلالات سلامت روان در ژنتیک افراد مشخص میشود!
- رژیمهای غذایی گیاهی برای رهایی از بیماریها مفیدند!
- استفاده از گوشی همراه را چگونه متعادلتر کنیم؟
- گروههای پرخطر حتما واکسن آنفلوانزا تزریق کنند!
- معضل بیشفکری و رویاپردازی را چگونه حل کنیم؟
- داروهای گیاهی توانایی تقویت سیستم ایمنی را دارند؟
- پیاده روی میتواند با اسکوات جایگزین شود!
- میران استرس قابل اندازه گیری است!
- ارتفاع بالش بر فشارخون شما تاثیر دارد!
- شکلات تلخ میتواند پیری را به تعویق بیاندازد!
- احساس گناه در مادران شاغل ریشه در چه چیزی دارد؟
- نرخ فرزندآوری زنان چقدر است؟
- بوتاکس معده عوارض دارد؟
- خواص متعدد چای سیاه برای سلامت و زیبایی را از دست ندهید!
- گوشت فرآوریشده و پنیر میتواند باعث بیماری قلبی شود!
- رژیم گیاهخواری کمچرب مناسب برای کسانی که دیابت دارند!
- یکی از پرمصرفترین قارچکشهای جهان بر سلامت انسان تاثیر منفی دارد!
- بررسی مهمترین فواید کلاژن مایع!
- الان میتوانیم واکسن آنفلوآنزا بزنیم؟
- مهمترین نشانههای دیدار با نیمهگمشده!
- مکانیسم خمیازه در بدن چگونه است؟
- مارسلو الگوی خود در دنیای فوتبال را معرفی کرد
- عکس| هالند عکسی از آرشیو خود را با شیرر به اشتراک گذاشت و نوشت: «از توصیهات در سال ۲۰۲۲ متشکرم.»
- عکس| فلاویو بریاتوره در گرند پری فرمول یک با دیوید بکهام ملاقات کرد
- شانزده سال پس از مرگ او، گزارشی حقایق تکان دهندهای را در مورد کالبدشکافی این ستاره جهانی موسیقی پاپ فاش میکند
- خانواده بروس ویلیس با وخامت حال او، «تصمیمی دشوار» میگیرند
- کاردی بی از بند ناف فرزندش یک گردنبند طلا درست کرد
- مدونا مخفیانه با معشوق ۲۹ سالهاش نامزد کرده است
- کیت میدلتون و پرنس ویلیام به خاطر نحوه تشکر از کارکنانشان مورد انتقاد قرار گرفتهاند
- اشنایدر در یک نظرسنجی سریع به سوالات پاسخ داد: «کریستیانو رونالدو یا رافائل نادال؟»
- همسر سابق جنیفر آنیستون به رابطه نامشروع همسرش با یک متخصص هیپنوتیزم درمانی واکنش نشان داد
- کیران کالکین برای سومین بار پدر شد
- جزئیات رابطه عاشقانه سوفی ترنر با همسر سابق گوئینت پالترو فاش شد
- ریس ویترسپون در مورد رابطه جنیفر آنیستون با پیت: «او کسی نیست که به گذشته بچسبد.»
- رسوایی تکاندهنده درباره یک میلیاردر جهانی: او عاشق جفری اپستین، مجرم جنسی، بود، اما!
- جنیفر لارنس توضیح داد که چرا دیگر از ترامپ انتقاد نمیکند: «این کار به آتش ماجرا دامن میزند.»
- نحوه برخورد با شاهزاده هری و مگان مارکل در هالیوود فاش شد
- کیم کارداشیان گفت که به دلیل هوش مصنوعی در امتحانات حقوق خود رد شده است
- مشخص شد که چرا شاهزاده هری از مگان مارکل ناراضی است
- ریچارد گیر راز یک ازدواج شاد را فاش میکند: «من یاد گرفتم که پدر خوبی باشم»
- ستاره فیلم «ایفوریا» برای اولین بار درباره رسوایی تبلیغات شلوار جین صحبت میکند: «یک واکنش غیرمنتظره»
- آلکاراز: من بیشتر اسپانیایی هستم تا یک هوادار رئال مادرید
- کیتی پری دلیل جداییاش از اورلاندو بلوم را فاش کرد
- تیموتی شالامی برای اولین بار درباره رابطهاش با جنر صحبت میکند: «دوست دارم پدر بودن را تجربه کنم.»
- شوهر سابق جنیفر لوپز این بازیگر را به خیانت متهم کرد: «مشکل از خود توست.»
- دلیل واقعی نقل مکان کیت میدلتون به خانه جدید فاش شد
- جنیفر آنیستون درباره رابطهاش با یک متخصص هیپنوتیزم صحبت میکند: «غیرعادی»
- راز انتخاب گوشوارههای کیت میدلتون در محل کار فاش شد
- شوارتزنگر طرح خود را برای «حفظ دموکراسی» در ایالات متحده مطرح کرد
- سلنا گومز در پاسخ به انتقاد هیلی بیبر گفت: «او میتواند هر چه دلش میخواهد بگوید.»
- نظر جاستین بیبر در مورد اختلاف همسرش با سلنا گومز فاش شد
- مشخص شد که چرا پسر بکهامها سعی نمیکند با والدینش آشتی کند
- نیکول کیدمن پس از انتشار خبر طلاقش، میخواهد دوباره با کیث اربن رابطه برقرار کند
- ویکتوریا بکهام درباره قلدری در مدرسه صحبت کرد: «آنها به من میگفتند احمق.»
- دمی مور درباره شغل غیرمعمولی که در ۱۴ سالگی داشت صحبت کرد
- ستاره هالیوود پس از نبردی دردناک با زوال عقل، در بستر مرگ است
- «از صمیم قلب دلم برایت تنگ شده.» لیونل مسی از ورزشگاه بازسازی شده بارسلونا بازدید کرد
- همسر جاستین بیبر در بحبوحه رسوایی گومز، از برنامه خود برای فرزند دوم خبر داد
- کیرا نایتلی توضیح داد که چرا دخترانش را از استفاده از رسانههای اجتماعی منع کرده است
- کیم کارداشیان تغییر مسیر شغلی خود را اعلام کرد
- رامی ملک، بازیگر بینالمللی متولد مصر: برای گرفتن نقشم در این فیلم جنگیدم!
- تینا کندلاکی، ۴۹ ساله، راز ظاهر آراستهاش را فاش کرد
- رونالدو گفت که حتی ترامپ هم از او محبوبیت کمتری دارد
- مشین گان کلی معتقد است که او و مگان فاکس به دلیل چشم زخم از هم جدا شدند
- نامزد سابق تیماتی عوارض تزریقات زیبایی روی بازوهایش را نشان داد: "من هرگز به آن عادت نخواهم کرد. "
- یک دلیل غیرمنتظره آنجلینا جولی را مجبور میکند وارد یک دفتر استخدام نظامی در اوکراین شود
- کندال جنر اعتراف کرد که در کودکی به خواهرش حسادت میکرده است: «حسادت میکردم.»
- شوهر خواننده سیا او را به اعتیاد به مواد مخدر متهم کرد
- همسر ۶۱ ساله باراک اوباما راز زیبایی خود را فاش کرد: «من اخم نمیکنم».
- کیم کارداشیان رابطه اش با دختر ترامپ را فاش کرد
- دلیل نفرت شاهزاده ویلیام از شاهزاده اندرو فاش شد
- کیت میدلتون و ملکه کامیلا اصرار داشتند که شاهزاده اندرو از عناوین خود محروم شود
- دلیل اینکه کیت میدلتون و پرنس ویلیام نقل مکان به خانه جدید را تسریع کردند، فاش شد
- جنیفر آنیستون در کنار نامزد هیپنوتیزم درمانگرش در سریال «عشق من» بازی میکند
- مدونا مخفیانه با معشوق ۲۹ سالهاش نامزد کرده است
- ستاره جنجالی فیلم «ایفوریا» با نامزد سابقش در ماشین مشاجره کرد
- کیت میدلتون و پرنس ویلیام به خاطر نحوه تشکر از کارکنانشان مورد انتقاد قرار گرفتهاند
- ناسا به تردیدهای کیم کارداشیان در مورد فرود بر ماه پاسخ داد
- عکس| مل گیبسون جنجالی بر سر مریم مقدس به پا کرد
- ابتلا به «ویروس اهداکننده»| یک بازیگر مشهور آمریکایی قصد دارد کلیه خود را به یک غریبه اهدا کند
- همسر سابق آرشاوین: او بنتلی من را فروخت، یک مرسدس خرید و مابهالتفاوت را برای خودش نگه داشت
- حمایت بانکها از بازار سرمایه از فردا اجرا میشود
- بورس سقوط کرده در دولت روحانی چگونه در دولت شهید رئیسی احیا شد؟
- درمان بورسی پزشکیان از زبان عبده
- جذب سرمایه ۷ همتی از بازار بورس دانشبنیانها
- وعده عناب بورسی واقعیتر شد
- چهارمین روز نزولی بازار در غیاب نیروهای صعودی
- انتخابات و دامنه نوسان مهمترین دلیل رکود فعلی بورس
- بورس با ۴ مصوبه دولت برای حمایت از بازار سهام سبزپوش میشود؟
- ۳ دلیل پایین بودن ارزش معاملات خرد در بورس
- معافیتهای مالیاتی بازار سرمایه باید استمرار پیدا کند
- بورس این روزها تحت تأثیر تداوم نرخ اخزای بالای ۳۵ درصد
- رشد شاخصهای بورس با کف سازی تکنیکال
- کاهش دامنه نوسان هم علاج بورس نزولی نبود
- سایه تامین مالی دولت بر سر بورس سنگینی میکند
- کاهش بی سابقه حجم معاملات سهام در بورسهای جهانی
- رشد شاخصهای بورس با کمک بانکیها و اعلام نرخ تسعیر ارز
- حمله به سفیر روسیه در لهستان
- معرفی سری گوشیهای Redmi K ۵۰ قبل از رونمایی رسمی
- غفوری: فکر کردن به قهرمانی از الان، سادهلوحانه است
- کاهش ۱۰ درصدی تولید هوندا در دو کارخانه
- سومین نشست دستمزد، باز هم بدون نتیجه
- لغو بلیت فروشی عمومی المپیک زمستانی چین
- گرامیداشت قربانیان هواپیمای اوکراینی در دانشگاه تورنتو
- ادامه چانهزنی چهارگانه در وین
- صرفهجویی ۱.۶ میلیارد دلاری کمیته برگزاری المپیک و پارالمپیک توکیو
- محبوبترین رشته المپیک توکیو مشخص شد
- اعلام هزینه میزبانی توکیو از المپیک و پارالمپیک ۲۰۲۰،
- آذرتاج: هیات اقتصادی جمهوری آذربایجان به ایران میرود
- بررسی عملکرد ایران در المپیک؛ جایگاه چهارمی در آسیا
- پایان وضعیت اضطراری در کشور میزبان المپیک ۲۰۲۰
- سریعترین منبع گلوکز| مزایا و معایب شکر سفید
- زنجبیل... طعمی متمایز و فواید بیشماری برای سلامتی!
- تاثیر سبکهای فرزندپروری بر سلامت روان نوجوانان
- شکلات تلخ چگونه بر سن بیولوژیکی انسان تأثیر میگذارد؟
- چگونه وضعیت خوابیدن میتواند سلامت جسمی و عصبی را تهدید کند؟
- غذاهایی که در کاهش فشار خون و بهبود سلامت رگهای خونی مؤثر هستند
- نکات ضروری برای حفظ سلامت و استحکام استخوانها
- این کاگاه زن، مارپل ایرانیست
- چرا بایرن مونیخ درها را به روی محمد صلاح بست؟ پنج دلیل قاطع حقیقت را آشکار میکند
- کشف دلیل افزایش خطر ابتلا به بیماری قلبی و دیابت در سالمندان
- علائم زوال عقل که ممکن است در عصر ظاهر میشوند، شناسایی شدهاند
- یک آسیبپذیری جدید، امیدهایی را برای درمان آسم آلرژیک ایجاد میکند
- عوارض کمبود ویتامین B۶ مشخص شده است
- یک عنصر حیاتی| بهترین منابع غذایی منیزیم
- متخصصان تغذیه ضروریترین مکملهای ویتامینی را معرفی کردهاند
- منبع غنی ویتامین C و اسید فولیک| فواید لیمو در رژیم غذایی
- چشم پزشک، خوددرمانی را برای مشکلات چشمی توصیه نمیکند
- اقدامات پیشگیرانه در برابر سرماخوردگی و آنفولانزا
- روزهداری متناوب نتایج بهتری در کاهش وزن نشان میدهد
- اگر حشرهای چشم شما را نیش زد، چه کاری باید انجام دهید؟
- یک مطالعه در عربستان سعودی، تأثیر اضطراب و بیخوابی را بر سیستم ایمنی بدن آشکار میکند
- انگور به افزایش طول عمر کمک میکند
- شام سالم: وعدههای غذایی متوسط و فعالیت بدنی بعد از غذا از وزن و هضم غذا محافظت میکند
- اثرات مفید خوردن موز هر روز مشخص شده است
- سازمان بهداشت جهانی: علائم طولانیمدت کووید-۱۹ همچنان یک مشکل جدی است
- پیادهروی بعد از شام میتواند سلامت قلب شما را بهبود بخشد
- مقامات بهداشتی روسیه یک داروی ایمونوتراپی نوآورانه برای سرطان ریه را ثبت کردند که کاملاً در داخل کشور تولید خواهد شد
- انگور میوهای عالی برای طول عمر نامیده میشود
- روشی ساده برای کاهش سرعت زوال شناختی در بیماران پارکینسون
- هفت دلیل برای اینکه پیادهروی نوردیک بهتر از پیادهروی معمولی است
- تابستانهای گرمتر ممکن است در افزایش موارد سرطان پوست نقش داشته باشند
- عفونت شایع ریه خطر ابتلا به بیماری قلبی را افزایش میدهد
- توصیههایی در مورد چگونگی آمادهسازی بدن برای فصل سرما ارائه داده شد
- مکملهای روغن ماهی فواید قلبی عروقی مهمی برای بیماران دیالیزی دارند
- پنج عامل که خطر ابتلا به فشار خون بالا را افزایش میدهند، نام برده شد
- علائم بالا بودن سطح ویتامین D در بدن
- متخصص تغذیه، درباره خطرات پنهان شیر گیاهی صحبت کرد
- شاخص جدیدی برای بیماری پارکینسون
- متخصص تغذیه، توصیههایی در مورد «مفیدترین گیاهان دارویی» ارائه داد
- ارز
- طلا
- بورس
- تورم
- اخبار داغ
- ورزشی
- پربیننده
- پربحث
- استراتژی ترامپ و جنجال «ایکس» در حال تبلور شکاف بیسابقهای بین آمریکا و اروپا است
- چهار کشور اروپایی در مورد استفاده از داراییهای روسیه اظهار نظر کردهاند
- در مورد نوشیدنیهایی که علائم سیستیت را بدتر میکنند، گفته شد
- پوتین: دادگاه حقوق بشر اروپا کاملاً سیاسی شده است
- با وجود توافق صلح با میانجیگری آمریکا، بیش از ۴۰۰ غیرنظامی در پی از سرگیری درگیریها در شرق کنگو کشته شدهاند
- اتحادیه اروپا در مورد زمان مسدود کردن داراییهای روسیه اظهار نظر کرد
- علت احتمالی از دست دادن بینایی در دیابت شناسایی شد
- پوتین هدف جدیدی را تعیین کرد: کاهش نرخ فقر در روسیه به کمتر از ۵ درصد تا سال ۲۰۳۶
- مرتز فاش کرد که در جریان تماس تلفنی رهبران اروپایی و ترامپ درباره اوکراین چه اتفاقی افتاده است
- رئیس جمهور فنلاند معتقد است که صلح در اوکراین بیش از هر زمان دیگری نزدیک است
- دانشمندان کشف کردهاند که چگونه آفتابپرستها میتوانند کره چشم خود را به صورت جداگانه حرکت دهند
- تلاشی برای احیای محبوبیت «فیسبوک»
- یک مقام دولت بایدن طعمه شیادان روس شد
- ترامپ گفتگوی خود با نخست وزیران تایلند و کامبوج را در بحبوحه درگیری بین این دو کشور ارزیابی کرد
- کشف شده است که افرادی دارای یک "حس هفتم" پنهان هستند
- مامور سابق اطلاعاتی اوکراین نفوذ نولاند و واشنگتن را در جریان رویدادهای میدان در کییف فاش کرد
- روسیه از تجربه چین در تنظیم مقررات هوش مصنوعی الهام میگیرد
- اتحادیه اروپا داراییهای روسیه را به طور دائم مسدود کرده است
- روسها در مورد خطرات تزریق بوتاکس هشدار دادند
- رئیس باشگاه الخلود به باشگاههای سعودی در مورد جذب صلاح هشدار داد| بهتر است ستارههایی مثل وینیسیوس جذب شوند
- ۶۰۰ اثر باستانی از موزه بریتانیا به سرقت رفته... و تأخیر مرموز در افشای این حادثه
- روسای دولتهای بریتانیا و بلژیک نقطه عطفی را برای اوکراین اعلام کردند
- ژنرال لهستانی: اگر روسیه به کشورهای ناتو حمله کند، این ائتلاف ممکن است وارد کالینینگراد شود
- زاخارووا: کنفرانس روسیه و آفریقا در قاهره روابط مسکو با این قاره را تقویت خواهد کرد
- روته از کشورهای اروپایی خواست برای مبارزه با روسیه آماده شوند
- مرتز: هیچ کمک اضافی به اوکراین در سال ۲۰۲۶ ارائه نخواهد شد
- سند فاش شده: آمریکا میخواهد چهار کشور را از اتحادیه اروپا جدا کند و دلیل آن تکان دهنده است
- رسانهها از نگرانی اپوزیسیون مجارستان در مورد ریاست جمهوری اوربان خبر دادند
- وزارت امور خارجه آمریکا برای ارائه اطلاعات در مورد سرکرده یک باند تبهکار، ۵ میلیون دلار جایزه تعیین کرده است
- گزارشی تکاندهنده از موارد تجاوز و خشونت جنسی علیه زنان در سودان
- بریتانیا گفت که مرتس تنشهای بین اتحادیه اروپا و ایالات متحده را «کماهمیت جلوه میدهد»
- شورای اتحادیه اروپا اختصاص ۲.۳ میلیارد یورو به عنوان قسط منظم کمکهای اروپا به اوکراین را تصویب کرد
- او سعی کرد او را در خیابان ببوسد... یک مرد مصری به جرم آزار و اذیت یک کارآموز زن در یک سازمان ملل متحد دستگیر شد
- اوکراین به کمیسیون اروپا قول داده است که تا سال ۲۰۲۶ یک برنامه مبارزه با فساد را تصویب کند
- دانشمندان یک "وصله" برای ترمیم قلب بدون جراحی پیچیده ایجاد کردهاند
- سیبیاس نیوز: نیروهای ویژه عملیاتی را برای انتقال ماچادو، رهبر مخالفان ونزوئلا، به نروژ سازماندهی کردند
- درخواستهای رسمی از فیفا برای توقف فروش بلیت جام جهانی ۲۰۲۶
- بانکهای بریتانیایی علیه توقیف داراییهای مسدود شده روسیه موضع گرفتهاند
- یک پزشک افسانهی اثرات مضر نخوردن صبحانه را رد کرد
- شمشهای طلای تقلبی مصر را فرا گرفتهاند... حقیقت پشت نگرانیهای رسانههای اجتماعی چیست؟
- کاخ سفید: ترامپ از جلسات متعدد در مورد اوکراین خسته شده و احساس ناامیدی میکند
- اوربان متهم شده است که به دنبال تغییر نظام حکومتی در مجارستان است
- راهی برای محافظت از مغز در برابر اثرات سکته مغزی پیدا شده است
- زلنسکی بار دیگر خروج نیروهای کییف از جمهوری خلق دونتسک را رد کرد
- نخستوزیر اسلواکی: اتحادیه اروپا در آستانه فروپاشی است
- معاون نخست وزیر بلژیک گفت که در «مرحلهای» داراییهای روسیه باید توقیف شود
- یک روش غیرآشکار برای مقابله با افسردگی بدون دارو معرفی شده است
- ووچیچ: صربستان آماده است تا بهای معقول و مناسبی برای NIS بپردازد
- سناتور روس نسبت به «استعمار معکوس» بریتانیا از طریق مهاجرت هشدار داد
- آمریکا، اوکراین و اتحادیه اروپا مذاکرات جدیدی را در مورد طرح ترامپ برگزار خواهند کرد
- یک راه ساده برای جلوگیری از آسیب دیدگی هنگام دویدن شناسایی شده است
- زاخارووا: بریتانیا با اذعان به مرگ یکی از سربازانش، افکار عمومی را برای خسارات خود در اوکراین آماده میکند
- دهها غیرنظامی در حمله نیروهای ویژه آموزش دیده توسط آمریکا در سومالی کشته شدند
- اتحادیه اروپا روندی را برای «مسدود کردن بلندمدت» داراییهای روسیه آغاز کرده است
- عاملی که خطر کم شنوایی را چهار برابر افزایش میدهد، شناسایی شد
- خودران: مسکو قرار است اولین سیستم متروی بدون راننده خود را راهاندازی کند
- یک چهارم جمعیت آلمان تا سال ۲۰۳۵، ۶۷ سال یا بیشتر سن خواهند داشت
- کرملین در مورد ایده آمریکا برای ایجاد جایگزینی برای گروه هفت با روسیه اظهار نظر کرد
- دانشمندان برای اولین بار موفق به ترجمه سیگنالهای مغزی به متن معنادار شدند
- ترامپ: ما در حال مذاکره در مورد خلع سلاح هستهای با روسیه و چین هستیم و همه به دستیابی به آن علاقهمندند
- «تصمیم با ما نیست»: فون در لاین به حمله ترامپ به اروپا پاسخ میدهد
- وزارت امور خارجه روسیه در مورد وضعیت پیرامون ایالات متحده و ونزوئلا اظهار نظر کرد
- علامتی شناسایی شده است که خطر مرگ در بیمارستان را شش برابر افزایش میدهد
- سیل در رودخانه اسکاگیت در واشنگتن به بالاترین سطح خود رسید و دهها هزار نفر را مجبور به تخلیه کرد
- کلمبیا آمادگی خود را برای اعطای پناهندگی به مادورو اعلام کرد
- ترامپ از رهبران اروپایی خواست تا به زلنسکی فشار بیاورند
- دانشمندان برای اولین بار ماهیت هوش انسانی را آشکار کردند
- بانک مرکزی روسیه از یوروکلیر شکایت کرد
- با یک قرارداد هنگفت، الولید بن طلال هواداران الهلال را غافلگیر کرد
- سفارت آمریکا، ناتو و اتحادیه اروپا را به آماده شدن برای درگیری با روسیه متهم کرد
- دانشمندان توضیح دادهاند که چرا کاهش وزن بسیار دشوار است
- اردوغان: ترکیه آماده حمایت از ابتکارات برای حل و فصل مسالمتآمیز بحران اوکراین است
- رسوایی آزار و اذیت در پارلمان ترکیه
- یک وزیر مجارستانی پیامدهای پیوستن اوکراین به اتحادیه اروپا را توضیح داد
- نشانهای از خطر بالای سکته مغزی پس از ۷۰ سال شناسایی شده است
- موضع اروپا در قبال اوکراین، آمریکا را خشمگین کرده است
- دانشمندان روسی به هوش مصنوعی آموزش دادهاند تا مواد آینده را خلق کند
- کالاس درباره رسوایی بزرگ کلاهبرداری که اتحادیه اروپا را لرزاند، اظهار نظر میکند
- یک فاجعه انسانی در سواحل یونان؛ اکثر قربانیان اهل مصر و سودان هستند
- اتحادیه اروپا تخصیص بخش جدیدی از کمکهای مالی کلان به کیف را تصویب کرده است
- دو گزینه برتر برای تیم ذخیرههای بارسلونا
- تصمیم نهایی توسط دایوت اوپامکانو
- آرن اسلات دوباره درباره محمد صلاح صحبت میکند
- «نتیجه گفتگوی ما فردا مشخص خواهد شد.» آرن اسلات درباره محمد صلاح
- گرسون در مورد اخبار مربوط به جدایی احتمالیاش از زنیت اظهار نظر کرد
- الساندرو دل پیرو در مورد اهداف یوونتوس در این فصل صحبت کرد
- برزیل تصمیمی جدی در مورد کارلو آنچلوتی گرفت!
- حمله زمستانی توسط آنتونیو رودیگر
- وقتی داوید سیلوا میتوانست به رئال مادرید برود
- جیکوبز: مالینوفسکی در تابستان بازیکن آزاد خواهد شد و یوونتوس و اینتر به او علاقهمند هستند
- آ اس: اخراج ژابی آلونسو از رئال مادرید فقط مسئله زمان است
- الیور کان: ایدههای ژابی آلونسو به رئال مادرید نمیخورد، این باشگاه به مربی دیگری نیاز دارد
- روبرت لواندوفسکی شرایط خود را برای آینده تعیین کرد
- سویا به ۹ میلیون یورو فوری نیاز دارد
- رئال اویدو و ختافه هدف مشترکی در اسپانیول دارند
- لوکا مودریچ: از بچگی طرفدار میلان بودم
- «آلونسو لبهای نازکی دارد.» اورلوف دلیل غیرمنتظرهای را برای مشکلات رئال مادرید شناسایی کرد
- ژولیان آلوارز، مهاجم اتلتیکو مادرید به گزارشهای مبنی بر انتقال به بارسلونا واکنش نشان داد
- خبر مهم لوئیس انریکه برای نقل و انتقالات زمستانی
- لیورپول در مورد صلاح تصمیم میگیرد
- پیشنهاد ۲۴ میلیون یورویی برای ماریو گیلا: رئال مادرید در حال بررسی است
- اورلوف: ماتوی سافونوف آدم فوقالعادهای است! ادامهی مکتب شورویِ لو یاشین
- طبق گزارش ترانسفرمارکت، امباپه و یامال گرانترین بازیکنان لالیگا هستند
- صلاح در مورد اختلافش با باشگاه با بازیکنان سابق لیورپول مشورت کرد
- مارکوس رشفورد اعتراف بزرگی میکند
- پیشنهاد بزرگی که سرخیو هررا رد کرد
- دنزل دامفریس، فرصتی ۲۵ میلیون یورویی
- استون ویلا طولانیترین روند پیروزیهای متوالی باشگاه از سال ۱۹۱۴ را ادامه داد
- کانچلسکیس در سفرش به انگلیس: من تابعیت دوگانه دارم، مشکلی ندارم
- آلوارو موراتا به دلیل مصدومیت از ناحیه ران، مدت زیادی از میادین دور خواهد بود
- لوکا سوچیچ در حال حاضر دو گزینه خروج دارد
- نبرد پنججانبه اثر عثمان دیوماند
- تصمیم رئال بتیس در مورد سرجی آلتیمیرا
- اسلات پیش از بازی لیگ برتر مقابل برایتون، درباره مصدومیت بازیکنان لیورپول صحبت کرد
- «او سطح خودش را نشان داد.» انریکه از عملکرد سافونوف در دو مسابقه اخیر پاری سن ژرمن تمجید کرد.
- اسلات فاش کرد چه کسی تصمیم به کنار گذاشتن صلاح از فهرست تیم برای مسابقات لیگ قهرمانان اروپا گرفته است
- آخرین اخبار پزشکی پاری سن ژرمن پیش از سفر به متز
- اوماها: روبرتو دی زربی در مورد امینه گوئیری اطلاعات جدیدی ارائه میدهد
- توپ طلا، مسی... روبرتو دی زربی و المپیک مارسی از میسون گرینوود هیجانزده هستند!
- آرتتا پیش از بازی با ولورهمپتون در لیگ برتر، در مورد مصدومیت بازیکنان آرسنال صحبت کرد
- واکنش لوئیس انریکه در پاسخ به این سوال که آیا سافونوف میتواند در پاری سن ژرمن زمان بازی بیشتری به دست آورد یا خیر
- سمین: سافونوف برای بهترین تیم دنیا بازی میکند - او باید فراتر از تواناییهایش عمل کند
- PSG: لوئیز انریکه نگران مارکینیوس نیست
- پاری سن ژرمن: لوئیس انریکه به تمجید از ماتوی سافونوف پرداخت
- الجزایر: یانیس زواوی، کاندیدای معتبر در فهرست ولادیمیر پتکوویچ
- کاپلو مزیت بازی باشگاههای انگلیسی نسبت به باشگاههای ایتالیایی را توضیح داد
- کارنو، روزنامهنگار: زیدان سرمربی رئال مادرید نخواهد شد
- صلاح آماده انتقال به رئال مادرید، بارسلونا یا بایرن مونیخ است
- پائو: دیلم مداح هوسها را برمیانگیزد
- محمد صلاح در مورد آیندهاش صحبت میکند؟ دوربینها او را شکار کردند
- رئال مادرید روی ژرمی ژاکه، بازیکن جوان فرانسوی برای خط دفاعی شرط بندی کرد
- لوتار ماتئوس در مورد ژابی آلونسو: برای او، مهمترین چیز بازیکن نیست، بلکه تیم است
- دیاز، مربی رودینا، مشاجرهاش با مورینیو در فینال لیگ اروپا را روایت میکند
- آموریم روی مانت: او بازیکن بااستعدادی است، اما گاهی اوقات نیاز دارد که از روی نیمکت بازی را شروع کند
- دیگو سیمئونه راز رابطه بین فوتبالیستها و مربی را فاش میکند
- آرسنال به دنبال دستیار ویکتور گیوکرس است
- هانسی فلیک از صحبت کردن در مورد رئال مادرید طفره میرود
- هافبک سابق لیورپول درباره آینده صلاح در این باشگاه صحبت کرد
- ویتینیا درباره نقش لوئیز انریکه در دوران حرفهایاش صحبت کرد
- مدافع سابق رئال مادرید، کاندیدای جدید جانشینی ژابی آلونسو
- اعلام خبر جنجالی درباره آینده یورگن کلوپ
- جانشین محمد صلاح در رئال مادرید؟
- اینترمیلان در حال آمادهسازی برای یک خرید ۲۵ میلیون یورویی است
- کونور: میلان به لونین علاقه دارد و مودریچ میتواند این بازیکن اوکراینی را برای پیوستن به باشگاه ایتالیایی متقاعد کند
- سرژ گنابری در مورد روند تمدید قراردادش با بایرن مونیخ اظهار نظر کرد
- اسکای اسپورت آلمان: شلوتربک میخواهد به رئال مادرید یا بایرن مونیخ برود
- یورگن کلوپ این موضوع را به صراحت اعلام کرده است
- مشکلی که رئال مادرید حل نکرده است
- رودریگو دی پل ۱۵ میلیون یورو در خزانه اتلتیکو مادرید میگذارد
- مکسی رودریگز درباره مسی و رونالدو: آنها بهترین ویژگیهای یکدیگر را شکوفا کردند
- لوکاکو اولین جلسه تمرینی خود را پس از چهار ماه به پایان رساند
- منچستریونایتد به یک مدافع ۳۰ میلیون یورویی لالیگایی علاقه دارد
- اولتیماتوم برای ژابی آلونسو
- آیا رایو وایکانو به آفیمیکو پولولو علاقهمند بود؟
- سرژ گنابری، تقویت خاموش
- لوورن، مدافع سابق لیورپول، در مورد وضعیت صلاح در این تیم اظهار نظر کرد
- بازیکن سابق منچسترسیتی درباره پستهایش در شبکههای اجتماعی اظهار نظر کرد
- لیورپول و منچستر یونایتد علاقه خود را به آردا گولر افزایش دادهاند
- مارک آندره ترشتگن، یک مشکل حل نشده
- جولین آلوارز پذیرای پیشنهادات است: «از علاقه بارسلونا ناراحت نیستم»




































































































